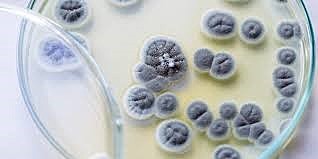
Descubrimiento de la penicilina e invención de los antibióticos

-
El sistema de alcantarillado, tal y como se conoce hoy en día, tiene su origen en la Europa del siglo XIX. Durante ese periodo, el pensamiento higienista extendió la idea de aplicar medidas para mejorar la sanidad en las grandes ciudades. Los primeros sistemas de alcantarillado, de los que se tiene referencia datan del 4.000 a.C.,
-
. Hacia el año 1440, se comenzó a buscar en Europa una sistema para poder distribuir textos de forma rápida. Johannes Gutenberg fue el pionero en introducir la imprenta de tipos móviles. Este avance en la tecnología, no solo fue una revolución a la hora de copiar los textos, sino que además supuso una evolución en la transmisión de nuevas ideas.
-
. A partir del siglo XVIII las mejoras sobre esta maquinaria produjeron el desarrollo de la industria, la sociedad y el transporte de la época. Provocando que los países de Europa comenzasen un proceso de industrialización.
-
en 1854 Antonio Meucci presentó el dispositivo nuevo de comunicación.
-
1876 El enorme desarrollo de la electrónica así como la invención y masificación del uso de los electrodomésticos incidió de forma crucial en la manera en la que hoy vivimos, en nuestra calidad de vida y en como apreciamos la realidad
-
En el año 1928 el bacteriólogo, médico y genetista inglés Frederick Griffiths dio los primeros pasos concretos sobre el camino de lo que hoy llamamos genética, desarrollando algunos de los conocimientos con los que hoy contamos sobre la estructura del Ácido desoxirribonucleico.
-
. En 1936 se desarrolla la primera computadora programable, una calculadora mecánica binaria que ocupaba toda una sala. No fue hasta la década de los setenta cuando se presentó el primer ordenador personal, creado por el ingeniero Edward Roberts. Este dispositivo electrónico fue el germen de una industria que evolucionaría llegando a proporcionar ordenadores nivel usuario.
-
1938 El cirujano Earl Tupper investigaba las propiedades del polietileno cuando tuvo la idea de los recipientes herméticos. Pero el gran logro fue la exitosa herramienta de marketing conocida como las “Tupperware Party”
-
En el año 1942 se construyó el primer reactor nuclear del mundo, en el llamado Proyecto Manhattan, con el se buscaba unan nueva fuente de energía que supuestamente no contaminaría, era más que eficiente e incluso parecía ser casi ilimitada.
-
En 1943 el ingeniero James Wright buscaba crear un caucho sintético. De su fracaso nació uno de los juguetes más populares de toda la historia.
-
(1946) La primera víctima de las microondas fue una barra de cacahuate. Estaba en el bolsillo del ingeniero norteamericano Dr. Percy Spencer, quien trabajaba en cierto rango de ondas emitidas por un magnetrón, un componente esencial en los radares. La barra se derritió, así que un intrigado Spencer aplicó el magnetrón a un huevo, el cual explotó.
-
Este simple invento que data de 1955, cuando apareció el primero, marcó un antes y un después en lo que a la transmisión de información concierne. Permitió desarrollar una generación tras otra de emisores y receptores de señales infrarrojas cada vez más sofisticados y cuyos usos, no se limitaron únicamente al de la televisión.
-
1957 De Mestral desarrolló un cierre que estaba formado por dos componentes: una tira de tejido con ganchos diminutos que se "acoplaba" a otra tira más pequeña de tejido con bucles que se unían temporalmente hasta que alguien los separara.
-
En 1958 William Higginbotham creó, sirviéndose de un programa para el cálculo de trayectorias y un osciloscopio, Tennis for Two (tenis para dos): un simulador de tenis de mesa para entretenimiento de los visitantes de la exposición Brookhaven National Laboratory.
-
fue un invento del químico Dr. Spencer Silver, quien trabajaba para la compañía 3M en el año de 1968 como Científico Ejecutivo en el Laboratorio de Investigación Corporativa.
-
. La red de redes que permite la interconexión descentralizada de distintos ordenadores, fue desarrollada en el año 1969, como un proyecto militar de Estado Unidos durante la Guerra Fría. Pero con el paso de los años, se ha convertido en una de las tecnologías de la comunicación clave, sobre todo en el nuevo milenio.
-
Con lo avances científicos y tecnológicos del siglo XX, esos sueños comenzaron a tomar forma y gracias a la invención del cohete, en el año 1969 el hombre pisó la luna y alcanzó un cuerpo celeste por primera vez en la historia.
-
1973 El Global Positioning System (o Sistema de Posicionamiento Global) es una tecnología desarrollada en la década de los setenta con fines militares por el ejército americano. Iván Getting, un físico e ingeniero electrónico, fue el inventor de este aparato que indica las coordenadas exactas de latitud y longitud gracias a su conexión con satélites.
-
En el año 1928 el escocés Sir Alexander Fleming descubrió las capacidades antibióticas de la penicilina presentes en el hongo Penicillium chrysogenum y hasta entonces, el mínimo error médico, una infección o cualquier tipo de herida, podía convertirse en un enorme y fatal problema.
-
Durante el siglo XX ocurrieron grandes avances en el campo de la anticoncepción y la lucha contra las enfermedades de transmisión sexual. Este es un echo fundamental en el desarrollo mismo de la humanidad.
Want to make a timeline like this?
Use Timetoast to turn dates, events, milestones, and phases into a clear visual timeline you can build and share. Timetoast is a timeline maker for work, school, research, and stories.